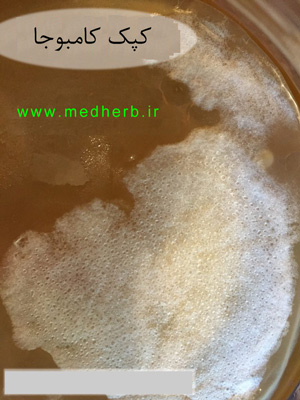
کپک کامبوجا - علایم کپک

کپک زدن کومبوچا (کامبوجا)
چطور کامبوجا کپک زده و کپک نزده را از هم تشخیص دهیم؟ و سپس چه کنیم؟
کپک زدن کامبوجا بسیار نادر است. در سالهای بسیاری از تخمیر، ما به ندرت با یک دسته کامبوجا کپک زده مواجه می شویم.
اگر یک هشدار کپک کامبوجا وجود داشته باشد، و از شما بخواهیم تا به طور جدی به آن رسیدگی کنید ، این است :

هرگز تلاشی برای نجات کامبوجا کپک زده نکنید : اگر متوجه شدید که کامبوجا آلوده شده ، آن را دور بریزید به همراه تمام متعلاقات آن که در ظرف قرار دارد. و دوباره با یک اسکوبی جدید و مواد جدید فرآیند را شروع کنید و تمهیداتی که در انتهای این مقاله می آید را به کار ببندید تا شاهد این کپک کامبوجا نباشید.
با این حال، قبل از دور ریختن کامبوجا مشکوک ، اطمینان حاصل کنید که واقعا کپک زده است. اغلب یک تازه وارد، تشکیل اسکوبی جدید یا برگه چای را در ظاهر اسکوبی به اشتباه معادل کپک زدن خواهد گرفت.که باعث می شود یک کومبوچای سالم را دور بریزند. برای رفع این مشکل ادامه مقاله و ظاهر کپک زدگی ها را دقیق مشاهده کنید تا بتوانید کپک واقعی را تشخیص دهید.
کپک زدگی چیست؟
کپک ها قارچ هایی هستند که در قالب فیبرهای چند سلولی به نام hyphae رشد می کنند. در مقابل، قارچ های میکروسکوپی که به صورت تک سلولی رشد می کنند، مخمر هستند. یک شبکه متصل از این hyphae شاخه ای لوله ای دارای هسته های چند هسته ای یکسان و یک ارگانیسم واحد است که به عنوان کلنی شناخته می شود.
کپک ها گروه بندی خاصی را به صورت طبقه بندی یا فیلوژنتیکی ایجاد نمی کنند، اما می توانند در بخش های Zygomycota، Deuteromycota و Ascomycota یافت شوند. برخی از کپک ها باعث بیماری یا فساد مواد غذایی می شوند، بعضی دیگر در تجزیه زیستی و یا در تولید غذاهای مختلف، نوشیدنی ها، آنتی بیوتیک ها و آنزیم ها نقش مهمی ایفا می کنند.
بدیهی است پس کومبوچا تا حدودی مرتبط به کپک است. تک سلول کپک مخمر نامیده می شود که یکی از مواد همان اسکوبی هست.در حقیقت ترجمه معنایی حروف کلمه چینی کومبوچا به معنای چای کپکی قرمز است.با این حال، ما درباره نوع کپک مورد بحث در اینجا اجتناب می کنیم. انواع معمولی کپک که ممکن است یک کومبوچا را از بین ببرد، همانند همان کپک هایی است که شما در نان یا میوه یا سایر اقلام غذایی میبینید.
شناسایی کپک کامبوجا
در زیر چند عکس از کوموبچای کپک زده شده امده است .

چه چیزی درباره این عکس قابل توجه است؟ کپک ها چه رنگی هستند؟ کپک ها در کجا قرار گرفته اند؟ کپم ها چه بافتی دارند؟
تقریبا همه انواع کپک کامبوجا :
- آبی - مشکی - سبز یا سفید / خیس یا خیلی خشک و یا تیره هستند
- در بالای اسکوبی قرار دارند - نه زیر آن و نه در لایه تعبیه شده است
- دقیقا مانند نوعی که تمام عمر خود را روی غذا دیده اید، به نظر می رسد
گالری عکس کپک کامبوجا :
کپک در کومبوچا بسیار نادر است و اگر چنین چیزی ظاهر شد باید کل محتوی کومبوچا دور ریخته شود.
این عکسها مثالهایی از کپک کومبوچا را فراهم کرده است. بنابراین قبل از انجام هر کار دقیقا کومبوچای خود را مشاهده کنید.
به غرایز خود اعتماد کنید - اما به یاد داشته باشید : کپک کومبوجا از زیر سطح تخمیر به وجود نمی آید. اگر چیز عجیبی در زیر مایع دیدید همان مخمر است. اما اسکوبی من ظاهر خنده داری دارد! آیا ناشی از ترس کپک است؟
حالا، فقط بخاطر اینکه کپک نزده دلیل بر این نیست که ظاهر اسکوبی خیلی خوب و صاف باشد. شکل و رنگ اسکوبی فرزند لزوما نشان دهنده کیفیت تخمیر شما نیست.
با توجه به بسیاری از عوامل، شکل گیری اسکوبی می تواند کاملا غیر معمول به نظر می رسد اما هنوز کاملا طبیعی است. در زیر تصویری از اسکوبی های سالم و عادی آمده است :




برای چشم غیر متعارف، این شکل ها عجیب و غریب به نظر می رسد در ابتدا اما به مرور زمان به فرایند آشنای تولید اسکوبی فرزند می شود. برای همین به تازه واردان توصیه میشود تا کومبوچا را حداقل 7 روز نگاه نکنند یا مزاحم آنها نباشند.
چرا کپک کامبوجا در مکان اول اتفاق می افتد؟
برای درک بهتر، اجازه دهید مروری بر فرآیند تخمیر داشته باشیم .یک دستورالعمل استاندارد کومبوچا شامل 90% چای شیرین محلول و 10% مایع اولیه است.مایع اولیه یا آغاز کننده نقش اصلی محافظت از اسکوبی را در برابر کپک زدن دارد.این چای کومبوچا بالغ دارای ph بین 2.5 تا 3.5 است - به اندازه کافی کم است برای ایجاد یک مانع طبیعی ضد میکروبی برای مهار رشد هر میکروارگانیسم خارجی. مایع شروع کننده به عنوان یک لایه محافظ عمل می کند تا زمانی که تمام مخلوط چای به اسکوبی جدید تبدیل شود - که حدود 3 روز طول می کشد تا pH مخلوط به مقدار 3.5 یا کمتر می رسد. و فقط در آن مدت حدود 3 روز است که پتانسیل رشد کپک وجود دارد.
ذرات کپک برای چشم انسان قابل مشاهده نیستند و می توانند در شرایط شدید به حالت خاموش شوند یا زنده بمانند.به همین دلیل است که توصیه نمی شود با آب یا سرکه بشویید.
چطور از کپک زدن کومبوچا جلوگیری کنیم؟
اگر مرتبا کومبوچا دچار کپک می شود. حتما مشملی در محیط و تمیزگی آن وجود دارد : آیا آب تمیز است؟ اگر مطمدن نیستید آن را برای 10 دقیقه بدون در بجوشانید. اگر ظرف دارای شیر است میبایست کنده شود و استریل گردد. به طوری که کپکی داخل آن نباشد. برخی از علل دیگر برای کپک عبارتند از: گرده افشانی از گیاهان خانه، سیگار کشیدن سیگار، رطوبت بیش از حد و دمای سرد.
نکاتی جهت جلوگیری از کپک کامبوجا :
1 . از مایع آغاز کننده ای استفاده کنید که در ذخیره اسکوبی داشته اید - یا هر کومبوچای قدیمی
2 . اگر مایع آغاز کننده قوی ندارید از مقدار بیشتری مایع اولیه فرایند قبلی استفاده کنید یا 1-2 قاشق غذا خوری سرکه سفید مقطر را در بالای مایع بریزید
3 . از وسایل گرمایشی در طول ماه های سرد برای گرم نگه داشتن ظرف تخمیر استفاده کنید.
4 . گیاهان خانگی را از مجاورت ظرف تخمیر دور کنید.
5 . اطمینان حاصل کنید که مقدار مناسبی جریان هوا وجود دارد
6 . اصلا در معرض دود سیگار قرار نگیرد.
در طول زمان شما مشاهده خواهید کرد که کپک زدن بسیار نادر است و کشف آن آسان است. و اصلا نیاز به ترس از کپک نیست و یا از تشکیل اسکوبی جدید. هر چقدر بیشتر اسکوبی های خود را مشاهده کنید بیشتر متوجه می شوید که آن یک فرآیند منحصر به فرد و یگانه است.








نظرات (29)